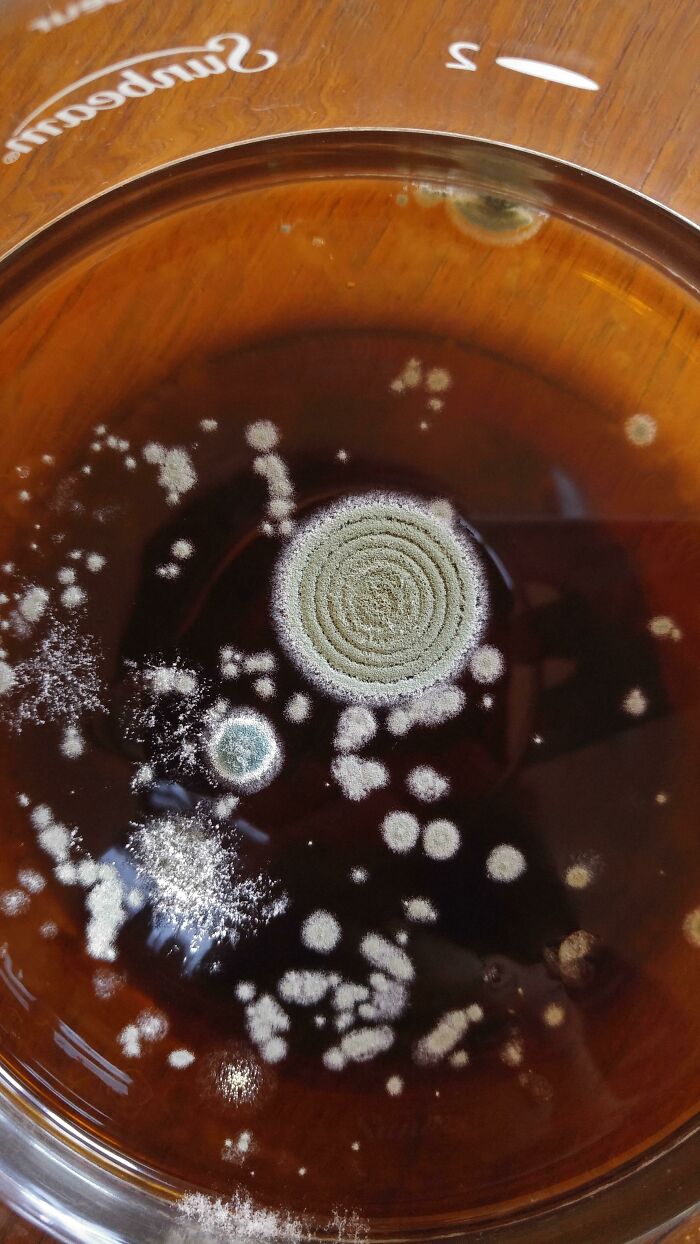

You gotta admit that it is a bit funny considering things can be mildly disgusting. Considering the physiological response to disgusting things, you either upchuck or you don’t. Sure, you can feel the urge, but again, you still reach a point where it’s too much or not enough. It’s more of an on the fence thing, and not a continuum, like comedy.
Still, the concept is more than worthy of a strong community backing it up. And, well, some of it is definitely more disgusting than just mildly, so be warned.
#1 When You Haven’t Cleaned Behind The Dresser In A Few Months

Image credits: puppydog000
#2 The Door I Had To Get Through Last Night To Get To My Room

Image credits: swimingle
#3 Tumor In Pork

Image credits: Royalflush0
Though the Mildly Disgusting community on Reddit is relatively modest in the grand scheme of things—clocking in at just 16,000 members—it’s an active and even dedicated one. And it’s ranked at the top 5%, and that’s saying something.
It’s essentially a place for all things “stuff that *almost* makes you want to puke.” It likely won’t, but some of it has great potential.
#4 “Black Hairy Tongue” A Condition Caused By Antibiotics

Image credits: mikehunnt
#5 This Customer Came In Today And Said “My Computer Doesn’t Turn On”.. Maybe Because It’s Infested With Roaches?!

Image credits: optemoz
#6 Toilet Snack Holders

Image credits: waternymph77
We’ve already discussed why disgusting and weird things draw us in so much in a few other listicles. If you haven’t caught that, it’s because there’s this evolutionary thing in our brains that essentially tells us “hey, that can be dangerous, focus on it like you’re a cat seeing something super foreign to them even though it’s just a baby.”
#7 This Cyst I Had Removed From My Back Today

Image credits: EhAhKen
#8 Get Right In There

Image credits: bigsamjapan
#9 Bean Croc

Image credits: DecMac360
It also ties in with the concept of benign masochism—a tendency where people deliberately seek out seemingly negative experiences to get a hit of that adrenaline rush within a limited degree of risk. There is definitely something exhilarating about seeing animals duke it out in the wild, and so that same thing can apply to mildly gross (or any degree of it) things.
#10 Our Pork Loin Had A Cyst

Image credits: Frat_Guy_PA
#11 My Cream Cheese That’s A Bit Expired

Image credits: abbygurl312
#12 Drank All The Milk From A Coconut...opened It Up And It Was Full Of Fungus

Image credits: flyingshowermat
And it doesn’t help that Reddit—in fact, any modern social medium—is designed in a way that it never ends and so the scrolling keeps on giving. Once you start looking at it, it’s sometimes hard to hit the brake pedal.
If you think it’s no big deal, 80% of Brits admit to scrolling things mindlessly, which averages to a total of 3 hours a day. Imagine what you could’ve done in that time.
#13 My & My Wife’s Exact Same Pillowcase (I Am 1/2 Portuguese, With Oilier Skin)

Image credits: chadywacker
#14 I Left A Banana In My Locker For About A Month

Image credits: TheActualPapaJohn
#15 I Cooked A Chilli Con Carne And Left It To Cool. Within Seconds A Fly Had Laid Eggs On It

Image credits: Mrdazjames
This also leads to the term doom scrolling—very appropriate for mildly gross content, if I might add—which is essentially the same as regular scrolling, but it focuses on that which is negative and bad. It doesn’t matter if it’s news, memes or any other kind of content found on social media. If it’s dark in nature, it fits.
#16 After Tearing Up Carpet At A Rental House; This Is How Much Dirt Was Under The Carpet

Image credits: xavierdaangel
#17 My Brothers Lunch For On The Road

Image credits: coolguypey
#18 I Bet Somebody Dropped The Cigarette, Was Probably Going To Pick It Up, Saw What Was There And Went "Nooope!"

Image credits: reddit.com
Folks speculate a number of reasons why scrolling, let alone doom scrolling, is so addictive. The most prevalent explanation is the idea of dopamine being associated with whatever that we can find on our phone through scrolling.
Other reasons include fear of missing out (what the kids these days call FOMO) and social media design, which, of course, will be designed in a way to keep you engaged because money.
#19 My Friend Made A Face Out Of Her Kidney Stones

Image credits: chadork
#20 Why Why Why

Image credits: reddit.com
#21 There's An Eel In This Scallop

Image credits: turdfurgison420
There are ways to kick the habit, namely creating phone free zones for yourself at home, setting time limits, and swapping scrolling for something else, like walks outside. It also helps to manage your notifications, unsubscribing from things and even consider digital detox.
#22 Don’t Run Barefoot In The Peruvian Jungle, Folks

Image credits: doofyduck
#23 The Scene At My Door This Sunday Morning

Image credits: skelution73
#24 Someone Used This Flea Comb At The Store To Remove Their Dandruff And Put It Back On The Shelf

Image credits: reddit.com
But, honestly, nobody would judge you for continuing on with your binges of all that is gross and disgusting, regardless of its level. Your body does a lot of debatably disgusting things that are actually good like farts, burps and other sorts of substances coming out whatever crevice that it comes out of. It’s your body’s way of getting rid of the bad stuff.
#25 Wtf My Little Brothers TV Has Ants

Image credits: Dragonzebra
#26 And Yet My Wife Still Complains About A Single Stray Beard Hair In The Sink. How She's Not As Bald As Me I Don't Know

Image credits: Invader-Strange
#27 At Least There's Room For The Driver

Image credits: autosdafe
Same goes with food. Something that looks or tastes disgusting might be very good for you. Eating means teaching your body’s immune system and gaining strength from its nutrients. Who cares if it looks, tastes and smells like a month-old armpit in liquid form. Add some salt. Bottom line is, not all that is disgusting is necessarily bad.
#28 Daughter Left Her Face Peel On The Dining Room Table

Image credits: Cantelon
#29 Marinade That’s Been Out For A Week

Image credits: un_tethered
#30 Cleaned Underneath My Keyboard

Image credits: Astroblizzy
So, what are your thoughts on any of this? Found anything disgusting lately that you’d rather not have, but, hey, you now have a reason to talk about it? Share your disgust in the comment section below!
But if it’s already too late for you to change your disgust-focused binge habits, you’re welcome.
#31 In Indonesia They Sell Whale Oil As A Drink For Children To Encourage Brain Function/Development

Image credits: mikehunnt
#32 The Way Mold Formed In My Coffee Pot
Image credits: CasusBellyBell
#33 Kiwi On A Pizza

Image credits: kalitarios
#34 2 Week Old Rice Has A Few Different Molds Growing In It

Image credits: j0llyllama
#35 Local Grocery Store Finally Decided To Move A Shelf After A Long Time

Image credits: KardIllusionist
#36 5 Days Post Tonsillectomy

Image credits: reddit.com
#37 A Moldy Vending Machine- In A Hospital

Image credits: IrradiatedMouse
#38 This Moldy Coffee Filter

Image credits: doctor_diamond
#39 The Applesauce My Friend Got With His Lunch

Image credits: ProducedByPotatoes
#40 Found The Smell

Image credits: kirby83
#41 The Build-Up Between The Double Glazing At My School

Image credits: weetabixbandit
#42 High Speed, Low Energy, Maximum Filth

Image credits: Mrdazjames
#43 Some Of My Biggest Tonsil Stones

Image credits: notrachelfromglee
#44 My Infected Ingrown Toenail

Image credits: anally_inclined-w-
#45 Broken Ashtray Under A T-Shirt

Image credits: PaulClair
#46 Ever Since I Moved Into The House I’m Renting My Clothes Kept Smelling Bad After I Washed Them And Then I Saw This

Image credits: Captain_cdiddy
#47 Finally Cleaned Out The Vacuum Cleaner Brush

Image credits: JohnMorningwood
#48 Found This In My Ear

Image credits: IOrangeJuiceI
#49 My Thumb Out Of Plaster Cast After Surgery To Reattach Tendon

Image credits: TheMoistKiwi
#50 About A Year And Half’s Worth Of Daily Disposable Contacts That Where I Tossed In A Cup That Stays In My Night Stand

Image credits: disSaysStufdNthingz
#51 The Pumpkin I Left Out On My Porch Since September 2019

Image credits: responsiblecrackhed
#52 Moved The Bed That Had Been There For 10 Years

Image credits: yismeicha
#53 My Scab Coming Off

Image credits: thynameisunidonk
#54 Washed My Boyfriends Winter Jacket

Image credits: thatMARISSA
#55 This Use To Be Clear

Image credits: reddit.com